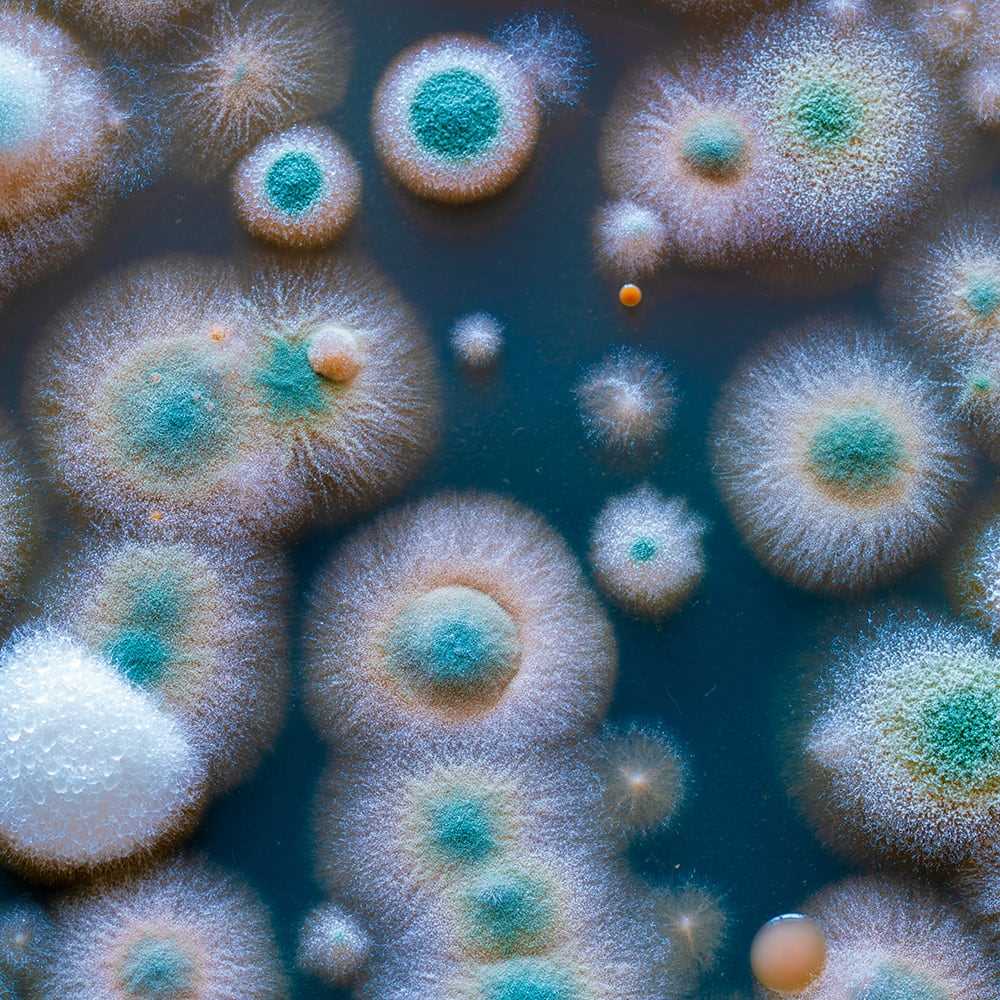
Pruebas no alimentarias

ALS es un proveedor global de servicios de prueba, inspección, auditoría y consultoría para los sectores de alimentos, bebidas y relacionados, capaz de proporcionar soluciones de alta calidad en una amplia gama de servicios, productos y ubicaciones. Nuestros equipos de laboratorio de alimentos cuentan con la experiencia y los conocimientos necesarios para apoyar a una variedad de sectores, entre ellos:

Nuestros laboratorios de microbiología tienen la experiencia y las capacidades necesarias para proporcionar una gama completa de pruebas en una variedad de ingredientes, productos en proceso y acabados, así como muestras ambientales. Hay una variedad de métodos de referencia y alternativos disponibles para cumplir con sus requisitos de especificación y respuesta.
MÁS INFORMACIÓN
Nuestros laboratorios moleculares especializados proporcionan pruebas de virus en muestras de alimentos y tienen la capacidad de analizar muestras ambientales para SARS-COV-2.
MÁS INFORMACIÓN
ALS gestiona los riesgos a través de un plan de gestión medioambiental con soluciones de prueba y servicios técnicos para revisar y apoyar sus acciones.
MÁS INFORMACIÓN
Nuestros laboratorios son capaces de determinar los componentes clave de los alimentos y las bebidas, incluidos los datos nutricionales, vitaminas, minerales y aditivos.
MÁS INFORMACIÓN
Los pesticidas y los agroquímicos se utilizan ampliamente, y las pruebas periódicas de los productos alimenticios garantizan que los residuos de estos compuestos permanezcan dentro de los límites legales.
MÁS INFORMACIÓN
Los alimentos pueden contaminarse de muchas fuentes, como los residuos industriales y ambientales. Nuestro equipo puede determinar si estos contaminantes están a niveles considerados seguros para el consumo.
MÁS INFORMACIÓN
Aunque los OMG están presentes en una amplia gama de alimentos, los OMG solo pueden utilizarse en circunstancias específicas y, a menudo, su presencia debe etiquetarse. Utilizando las últimas técnicas de biología molecular, ALS es capaz de identificar la presencia de OMG.
MÁS INFORMACIÓN
Es cuestión de salud pública identificar y etiquetar adecuadamente los alimentos que contienen alérgenos específicos. En todas nuestras ubicaciones globales, ALS puede ofrecer una pantalla completa de todos los alérgenos comunes en muestras de alimentos y medioambientales, incluidos todos los ingredientes alergénicos etiquetados obligatorios.
MÁS INFORMACIÓN
Aunque la gran mayoría de los alimentos son exactamente lo que se dice que son, en algunos casos, los alimentos pueden no ser exactamente lo que se afirma. En algunos casos, esto puede ser un riesgo para la salud pública. ALS puede autenticar que los productos alimenticios son lo que afirman ser.
MÁS INFORMACIÓN
Los materiales que estén en contacto con alimentos (envases de alimentos) no deben contaminar los alimentos. ALS es capaz de simular el contacto con alimentos para demostrar que toda la migración desde el envase está dentro de los límites definidos legalmente.
MÁS INFORMACIÓN
Nuestro laboratorio de excelencia de pruebas no alimentarias puede ofrecer una amplia gama de pruebas de productos.
MÁS INFORMACIÓN